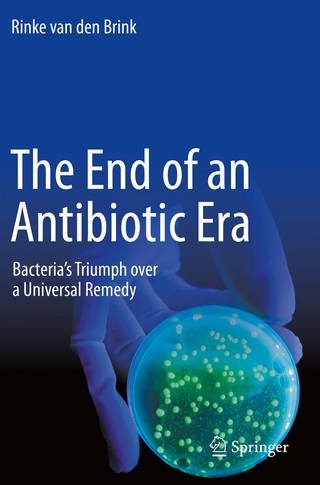
The End of an Antibiotic Era

eBook Download (PDF)
2023
|
Taylor and Francis
ISBN: 9781000852868
53,71 €
(CHF 52,45) (inkl. MwSt)
(CHF 52,45) (inkl. MwSt)
- Download sofort lieferbar